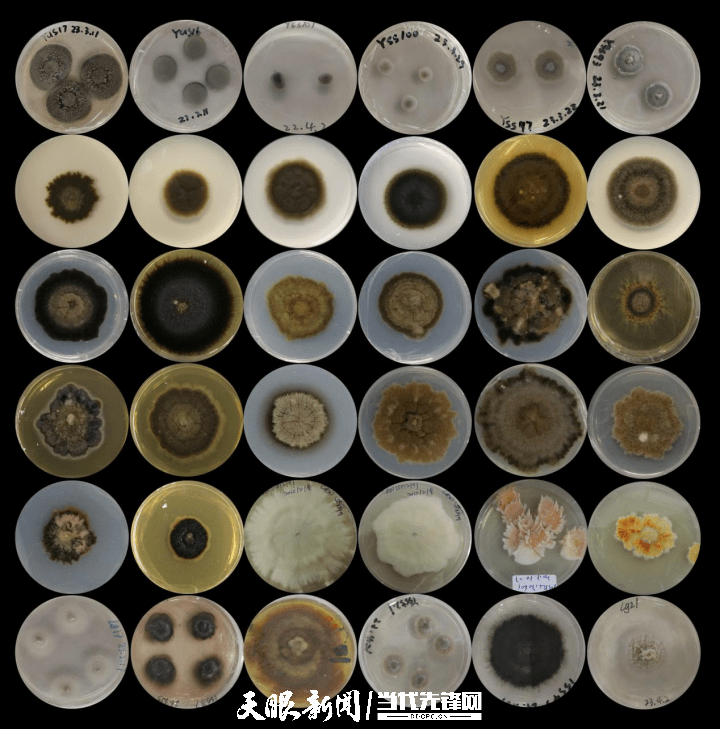

近日,记者走进贵州理工学院药用真菌资源研究室,宽敞明亮的房间中央摆放着巨大的实验台,台面上整齐排列着各种精密的仪器和试剂瓶,一台高大的显微镜坐落在实验台上,充满着科技的气息,通过它,食药用真菌资源多样性及开发利用团队带头人卢永仲和研究人员们正在观察着微小真菌的奥秘,并将相关数据上传至数据采集平台。

卢永仲和研究人员们正在研究新发现的真菌菌种
据悉,该团队与贵安新区科创产业发展有限公司合作开发的“工业微生物菌种选育数据采集平台”项目完成进度已达98%,该项目依托贵州本土丰富的真菌资源以及贵安新区贵安超算中心提供的强大算力,通过分子生物学相关技术和大数据手段提取贵州本土菌种包含DNA片段、物种亲缘关系及形态特征等生物信息上传至数据采集平台,打造贵州首个真菌菌株数据库。
部分菌株生物形态特征示意图
“黔地无闲草,夜郎多灵药。”生态为基,在贵州搭建“工业微生物菌种选育数据采集平台”,离不开得天独厚的地理环境优势。团队成员肖沅嫔说:“中国西南地区是全球虫生真菌资源最丰富的地区之一,同时贵州是药用植物资源最丰富的省份之一。黔产药用植物内生真菌因其独特的生存环境和与宿主植物的长期协同进化,能够产生具有多种生物活性和结构新颖的次级代谢产物。”来到恒温恒湿的菌株发酵室内,肖沅嫔正向记者展示团队新培育的卷旋型丝孢菌菌株,团队已经发表相关论文证明该类菌株能产生抗癌效果良好的生物活性物质,并将相关信息采集上传到数据采集平台当中,能够为未来的药品开发提供科学参考。

肖沅嫔向记者介绍卷旋型丝孢菌
“为科技创新输入澎湃动力。”算力赋能,依托贵安新区超算中心提供的强大算力支撑才能完成真菌菌株数据的采集上传。据了解,该团队自主研发的“工业微生物菌种选育数据采集平台”是打造国内自有真菌菌株数据库的重要尝试。“最近两个月时间内,我们依靠贵安超算中心提供的算力帮助,已经将新发现的100个菌种上传到数据采集平台,以往对新发现的单个菌种进行分析研究短则需要两三个月,长则需要一两年时间,其中针对物种亲缘关系的横向比较需要人工比对上万菌种,如今利用大数据AI分析技术最快只需要十几分钟便可以比对完一个菌株的DNA位点,节约了大量时间”肖沅嫔说。

贵安超级计算中心
真菌菌株数据库展现强大工业价值。“工业微生物菌种选育数据采集平台”交付之后,将应用到食药两用真菌精深加工技术研究等领域,有利于贵州本土真菌生物资源的开发利用,团队按照“向微生物要粮食”的“大食物观”发展战略,开展了蛹虫草、羊肚菌、红托竹荪、赤松茸等珍稀食药用菌优质蛋白质和多糖纯化工艺,以及小分子活性肽类产品的精深加工技术研究,已开发各类功能产品十余种,目前正在持续优化工艺路线,降低企业生产成本。
除此之外,据卢永仲介绍,利用贵州生态资源开发的真菌菌株未来还将“反哺”贵州生态环境,比如一些虫生真菌具有杀虫杀菌的生物活性,可以应用到生态农业生产领域,具有环境友好、对人体无毒害等特点,还有一些真菌具有分解白色塑料垃圾、重金属等生物活性,有助于环境污染治理。
贵州日报天眼新闻记者 张开学
编辑 龙海若
二审 徐然
三审 庞博